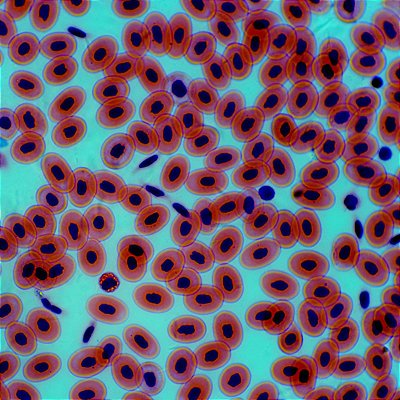

Opton
Microscópios, Estereomicroscópios e Acessórios
A Teratec destaca-se no mercado como fornecedora de uma vasta gama de produtos e equipamentos laboratoriais de excelência. Nosso portfólio inclui desde instrumentos precisos como microscópios e balanças, até recursos didáticos como modelos anatômicos e simuladores. Oferecemos também uma ampla seleção de vidrarias, insumos para biologia molecular como lamínulas e plásticos, além de ponteiras, meios de cultura, reagentes e muito mais. Nossa Equipe está à disposição!